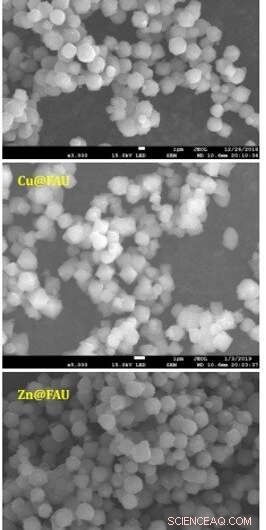
Fine‑Tuning Zeolite Pores for High‑Selectivity Alkyne/Olefin Separation

Adsorption data of C2H2 and C2H4 for Ni@FAU. (A) Adsorption isotherms of C2H2 and C2H4 for Ni@FAU at 298 K. STP, standard temperature and pressure. (B) TPD profiles of C2H2- and C 2H4-adsorbed Ni@FAU after their individual adsorption, co-adsorption, and successive adsorption (first C2H4 and then switched to C2H2) at 298 K. a.u., arbitrary units. (C) In situ FTIR spectra of Ni@FAU on adsorption of C2H2 and C2H4 followed by He purging (dotted lines) at 298 K. (D) Mass spectra of species produced by pulsed laser vaporization of the Ni@FAU target in the presence of carrier gas He, C2H2 (2%)/He, and C2H4 (2%)/He. m/z, mass/charge ratio; amu, atomic mass unit. Credit: Science, doi: 10.1126/science.aay8447
Organic chemists aim to separate alkenes such as ethylene and propene from alkynes before converting them into polymers. The technique has several drawbacks including hydrogenation of alkynes to produce unwanted alkanes, which has spurred an interest in other methods of separation. Zeolites, also known as molecular sieves, are crystalline solids made of silicon, aluminium and oxygen to retain cations, water and/or small molecules. However, most molecules cannot be efficiently separated with zeolites due to their size and volatilities. Researchers aim to efficiently remove alkyne impurities to produce polymer-grade lower olefins (unsaturated hydrocarbons), which remains challenging for many industries.
In a new report, Yuchao Chai and an international research team in advanced materials, chemical physics, neutron sciences and the Diamond Light Source in the U.K., U.S., and China developed a new strategy to control the interior pore of faujasite (FAU) zeolites. They achieved this by confining isolated open nickel(II) sites in their six-membered rings. Under ambient conditions, the Nickel (Ni) FAU sites (known as Ni@FAU) showed remarkable adsorption of alkynes and the efficient separation of acetylene/ethylene, propyne/propylene, and butyne/1-3, butadiene mixtures with unprecedented separation selectivity. Using in situ neutron diffraction and inelastic neutron scattering techniques, the team showed how confirmed nickel(II) sites allowed chemo-selective and reversible binding to acetylene by forming metastable [Ni(II)(C2H2)3] complexes. The ability to control the chemistry of pore interiors of easily sealable zeolites unlocked their potential to achieve challenging industrial separation. The work is now published in Science.
Chemical industries produce more than 350 million metric tons of lower olefins such as ethylene, propylene, and 1,3-butadiene by steam cracking hydrocarbons. The process of separating large quantities of chemical mixtures into purer forms contributes to enormous global energy consumption. In order to obtain polymer-grade olefins, scientists must also reduce the by-products of alkynes in the stream, as they irreversibly poison the catalysts for polymerization. State-of-the-art techniques that aim to purify olefins are based on partial hydrogenation of alkynes, but such methods are expensive and poorly selective. Emerging methods use porous sorbents such as metal-organic-frameworks (MOFs) for preferential adsorption of alkynes compared to olefins, but remain to be commercialized due to their inherently limited stability and high production costs. Zeolites are structurally robust and offer low-cost production with wide industrial separation applications due to their molecular sieve-like properties. However, they are ineffective for alkyne/olefin separation due to similarities in molecular size and volatility. The facile production and high stability of Ni(II) sites isolated into faujasite (FAU) zeolites to produce 'Ni@FAU' therefore reinforced their potential in industrial purification of lower olefins.
SEM images of Ni@FAU, Cu@FAU and Zn@FAU samples. Credit: Science, doi: 10.1126/science.aay8447
The team synthesized M@FAU zeolites; where M stood for Nickel—Ni(II), Copper—Cu (II) and Zn (II), using hydrothermal reactions of mixed gels and subsequent processing. They used a ligand abbreviated as TAPTS to coordinate Ni(II) ions for their inclusion in the zeolite pore structures at difficult locations. Using synchrotron X-ray powder diffraction data, the team confirmed M@FAU zeolite crystals to be in a specific cubic space group. They confirmed the homogenous distribution of transition-metal cations throughout the M@FAU crystals using electron microscopy and confirmed the divalent oxidation state of confined metal ions using X-ray photoelectron spectroscopy.
To confirm the primary location of the confined Ni(II) (nickel) sites in FAU zeolites, the scientists used density functional theory (DFT) calculations and in situ neutron powder diffraction (NPD) studies. During competitive adsorption of equimolar mixtures of acetylene (C2H2) and ethylene (C2H4) in the setup, Chai et al. observed the selective uptake of acetylene. They identified the adsorption species in C2H2- and C2H4- molecules loaded in Ni@FAU using mass spectrometry and identified fragments corresponding to Ni(C2H2)3 as a key species in C2H2-adsoprbed Ni@FAU. However, they did not observe Ni(C2H4)n (where n =1 to 4) species to form C2H4-adsorbed Ni@FAU. The results showed the highly selective adsorption capacity of acetylene (C2H2) in Ni@FAU alongside its ability to remove trace acetylene from the ethylene stream.

Column breakthrough studies for alkyne/olefin separations. (A) Column breakthrough curves for a C2H2/C2H4 (2%/2%) mixture using various zeolite samples at 298 K. C2H2 and C2H4 are shown in purple and orange, respectively. F, flow rate; F0, initial flow rate. (B) Effects of feed gas composition on C2H2/C2H4 separation over Ni@FAU at 298 K. (C) Plot of C2H2/C2H4 dynamic selectivity against C2H2 dynamic uptake under ambient conditions with state-of-the art sorbent materials. (D) View of recyclability of Ni@FAU for the separation of C2H2/C2H4 (2%/2%) at 298 K. Sample regeneration was achieved by treatment in He at 423 K for 30 min. (Eto G)Column breakthrough curves for propyne/ propylene (2%/2%) (E), butyne/1,3-butadiene (2%/2%) (F), and acetylene/ propylene (2%/2%) (G) over fixed beds packed with Ni@FAU at 298 K. Total gas flow, 6.0 mL/min; sample weight, 0.2 g. Credit: Science, doi: 10.1126/science.aay8447
Chai et al. conducted further experiments to separate C2H2/C2H4 mixtures using M@FAU (where M = Ni, Cu and Zn as before), under dynamic conditions. All experiments sufficiently adsorbed acetylene and produced ultrapure ethylene streams at the outlet. The dynamic uptake compared favorably with leading metal organic frameworks. The scientists noted further separation capabilities with Ni@FAU after increasing the column temperature or adding carbon dioxide or water into the gas stream. The results signalled the industrial potential of Ni@FAU for the adsorptive removal of alkynes from olefin streams. After 10 cycles of acetylene/ethylene separations with Ni@FAU, the team noted full sorbent regeneration between each cycle without declined retention for practical recyclability. In contrast, they noted poor reversibility with Cu@FAU. To evaluate the role of nickel in Ni@FAU, the research team introduced the metal ions into FAU zeolites via different methods such as ion-exchange and wet impregnation and showed minimal acetylene/ethylene separation. The scientists therefore credited the excellent performance of Ni@FAU to their binding methods and environments that efficiently confined nickel sites within the pores.
The team also identified the locations of confined nickel sites and adsorbed gas molecules (represented as C2D2, C2D4, C3D4 and C3D6) within Ni@FAU using in situ neutron powder diffraction studies. Based on Fourier difference map analysis of desolvated Ni@FAU, they confirmed the structural integrity and the absence of residual nuclear density within the supercage structure. After gas loading in the setup, they successfully interpreted the binding domains of gases via Fourier difference map analysis and Rietveld refinements (a technique to characterize crystalline materials).

Views of crystal structures for the Ni@FAU zeolite as a function of gas loading. All structures were derived from Rietveld refinements of NPD data at 7 K [Si and Al: yellow; O: red; Ni: green; C: gray; D: white; C 2D4 is highlighted in blue for clarity]. The host-guest interactions are highlighted by dashed lines, and the estimated standard deviation values for binding distances are typically within 0.02 to 0.08 Å. Views are of binding sites for adsorbed gas molecules in [Ni12Na20(Al44Si148O384)]·(C2D2)12 (A), [Ni12Na20(Al44Si148O384)]·(C2D2)26 (B), [Ni12Na20(Al44Si148O384)]·(C2D4)17 (C), [Ni12Na20(Al44Si148O384)]·(C3D4)20 (D), and [Ni12Na20(Al44Si148O384)]·(C3D6)26 (E). Credit: Science, doi: 10.1126/science.aay8447
All results were consistent with the characteristics of selective, yet reversible sorption noted in the study. The distinct nature of the sorbent-gas interactions validated the high selectivity of Ni@FAU toward alkyne adsorption. Chai et al. also visualized the binding dynamics of adsorbed C2H2 and C2H4 molecules on Ni@FAU with inelastic neutron scattering (INS) studies. Adsorption on to nickel sites resulted in the isolation and restriction of the gas molecules in an anisotropic environment, which resulted in distinct inelastic neutron scattering features. Allowing the team to verify the interactions between Ni@FAU and C2H2 (acetylene) to be stronger than that of Ni@FAU and C2H4 (ethylene).

INS spectra for Ni@FAU as a function of gas loading. (A) Comparison of INS spectra of C2H2-loaded Ni@FAU and that of solid C2H2.( B) Comparison of INS spectra of C2H4-loaded Ni@FAU and that of solid C2H4. Enlarged details show the translational or librational and the internal vibrational modes of adsorbed C2H2 and C2H4 molecules. Difference spectra were produced by removing signals of the bare zeolite and sample holder. Raw spectra are provided in the supplementary materials. Peaks are labeled with Roman numerals. S, dynamic structure factor; Q, momentum transfer; w, frequency change. Credit: Science, doi: 10.1126/science.aay8447
In this way, Yuchao Chai and colleagues demonstrated the increasing promise of solid-sorbent based techniques such as Ni@FAU (Nickel faujasite zeolites) to improve the operational efficiency of existing separation processes. At present, the techniques used for petrochemical industries and for the separation of alkyne impurities from olefins can only be realized by exploring differences in their dimensions, shapes, binding affinities and conformations. Scientists had previously considered zeolites with well-defined channels as viable candidates for gas separation for decades, primarily due to their molecular sieving property. Based on such studies, the team confined atomically dispersed nickel sites in the FAU zeolite channels in this work to form Ni@FAU and discriminate between alkyne and olefin binding. The work facilitated the production of polymer-grade olefins under practical conditions. The Ni@FAU sorbent offers an innovative and practical solution to the challenging process of separating alkyne/olefin compounds.
© 2020 Science X Network